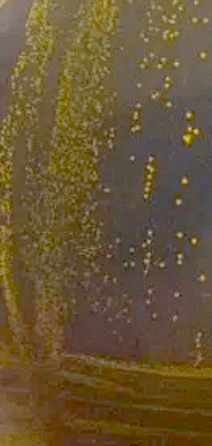

Integrating Ecological and Molecular Techniques to Address Questions in Microbial Physiology, Host-Microbe Interactions, and Nutrient Dynamics
Our laboratory is a community of learners. Our science can only thrive when we support and embrace our differences and our shared love for learning. Thus, in this lab, it is expected that we support one another and work to foster a positive learning environment for everyone.
News: We have wrapped up the the fall semester with some exciting times! Travel to Portugal for the World Sponge Conference (below) and we have some amazing undergrads in our lab working on culturing sponge microbes and improving our ability to hatch local freshwater sponges in the lab. Check out a student set-up of the ‘i-tip’ approach for enriching for sponge microbes (below). Our sponge DOM work is leading us into some exciting new directions for current and future students. Lastly, this fall was the first implementation of a Marine Science Lab class and we had a great trip to the NC coast! (also below)
And if you are on Instagram, check out our story with Waterlust for ‘Fieldwork Friday’ (you will have to log into your account to view the story)
Also a news update, I not been on Twitter since it changed to X, but now I am back on this type of platform and you can follow our lab activities at the same handle but through BlueSky Social: @spongesymbiont.bsky.social
Also, check out a youtube video make by an App State undergraduate student on our sponge microbiology research: https://youtu.be/W6NOO5rCEsY.

Check out our blogroll for field work blog posts – the most recent was in August 2024
Sponges are amazing animals that have a pivotal role in the structure and function of the ecosystems they inhabit. Sponges are known for their filtration capacity – filtering hundreds of liters of water per hour. Because of this ability, sponges can alter which nutrients, and the amount of nutrients, that are present in the water column. Most sponges also contain diverse microbial symbionts, which might be one reason sponges have survived for so long relatively unchanged (~600 million years). These organisms provide a relatively simple system for probing and asking questions about the ecology of symbiotic associations and about host-microbe interactions.

My research includes three main focus areas: symbiosis between sponges and microbes, nutrient cycling on coral reefs, and marine microbial ecology and physiology. Much of my work has been focused on the Caribbean and I currently have two NSF-funded projects to continue coral reef microbiology, but I also have a broad ecological and molecular background, having worked as a lab manager in a pulmonary research lab and on deep water sponge reefs, shallow temperate water habitats and laboratory grown cultures of marine microbes.

At ASU I have been focused on characterizing the diversity of freshwater sponges in Western North Carolina and understanding their ecology. I am also working on bioluminescence in marine dinoflagellates, the physiological response of marine algae to nutrient limitation, and anaerobic digestion of marine algae. More information about each of the major focus areas can be found using the links above.

To see sponge, microbe, and DOM related blogs from a successful crowd-funding project click here
Students in action




If you are interested in in joining the lab please email me at fiorec@appstate.edu. I am looking for motivated undergraduate and graduate students interested in marine ecological and/or molecular focused research.





